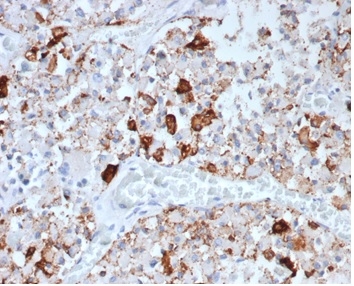

Formalin-fixed, paraffin-embedded human pituitary stained with Prolactin Recombinant Mouse Monoclonal Antibody (rPRL/4907).

IHC analysis of formalin-fixed, paraffin-embedded human brain. Negative tissue control using rPRL/4907 at 2ug/ml in PBS for 30min RT. HIER: Tris/EDTA, pH9.0, 45min. 2°C: HRP-polymer, 30min. DAB, 5min.

SDS-PAGE Analysis of Purified Prolactin Recombinant Mouse Monoclonal Antibody (rPRL/4907). Confirmation of Integrity and Purity of Antibody.

Analysis of Protein Array containing more than 19,000 full-length human proteins using Prolactin-Monospecific Recombinant Mouse Monoclonal Antibody (rPRL/4907). Z- and S- Score: The Z-score represents the strength of a signal that a monoclonal antibody (MAb) (in combination with a fluorescently-tagged anti-IgG secondary antibody) produces when binding to a particular protein on the HuProtTM array. Z-scores are described in units of standard deviations (SD's) above the mean value of all signals generated on that array. If targets on HuProtTM are arranged in descending order of the Z-score, the S-score is the difference (also in units of SD's) between the Z-score. S-score therefore represents the relative target specificity of a MAb to its intended target. A MAb is considered to specific to its intended target, if the MAb has an S-score of at least 2.5. For example, if a MAb binds to protein X with a Z-score of 43 and to protein Y with a Z-score of 14, then the S-score for the binding of that MAb to protein X is equal to 29.
Prolactin is a growth factor that is secreted by the anterior pituitary. It is necessary for the proliferation and differentiation of the mammary glands. Prolactin is useful in the classification of pituitary tumors and study of pituitary disease. It also plays a role in the development of mammary cancer, functioning dually as a mitogen and a differentiating agent.
There are no reviews yet.